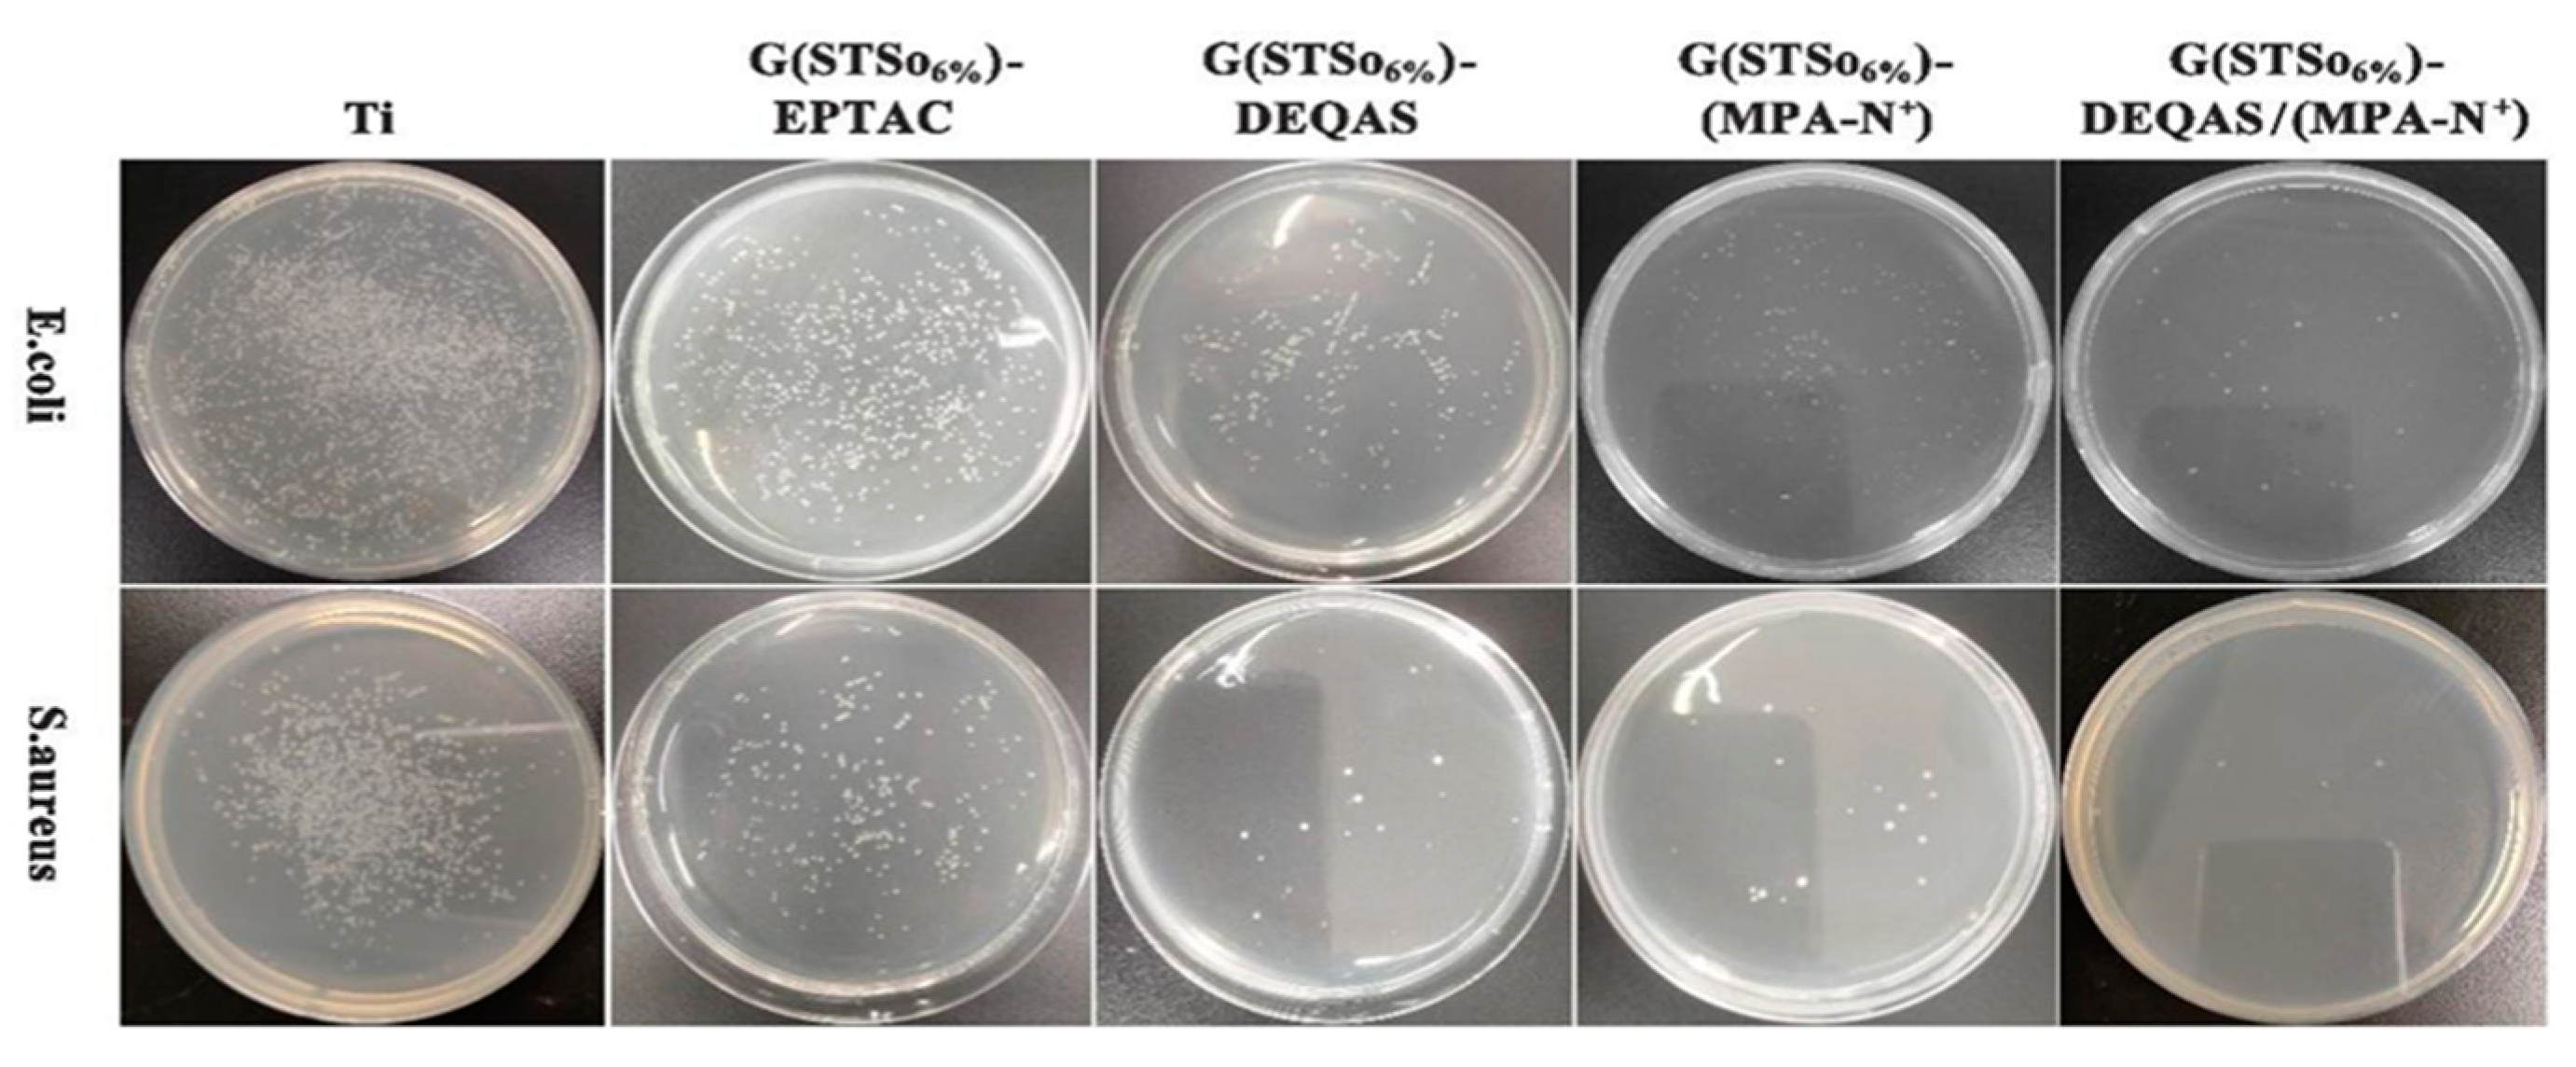
Molecules 28 04570 g009

Preparation of Gelatin-Quaternary Ammonium Salt Coating on Titanium Surface for Antibacterial/Osteogenic Properties
Abstract
1. Introduction
2. Results and Discussion
2.1. Calculation of Molar Grafting Rate
2.2. Determination of Wettability of Coating Surface
2.3. Analysis of Coating Surface Morphology
2.4. Determination of Surface Roughness of the Coating
2.5. Determination of Cell Adhesion on Coating Surface
2.6. Determination of Cell Migration on Coating Surface
2.7. Determination of Antibacterial Property of Coating Surface
3. Materials and Methods
3.1. Materials
3.2. Preparation of Collagen Peptide Solution
Synthesis and Characterization of DEQAS and MPA−N+
3.3. Preparation of Collagen Peptide−Quaternary Ammonium Salt Coatings
3.4. Nuclear Magnetic Resonance Hydrogen Spectroscopy (1H NMR) Characterization
3.5. Molar Grafting Rate Calculation
3.6. Optical Contact Angle (WCA) Measurement of the Coating Surface
3.7. Optical Microscopy (OM) Characterization
3.8. Atomic Force Microscopy (AFM) Characterization
3.9. Cell Adhesion Assay
3.10. Cell Migration Rate Determination
3.11. Determination of Antimicrobial Resistance
4. Conclusions
Author Contributions
Funding
Institutional Review Board Statement
Informed Consent Statement
Data Availability Statement
Conflicts of Interest
References
- Zhang, Q.; Liu, X.M.; Tan, L. An UV to NIR-driven platform based on red phosphorus/graphene oxide film for rapid microbial inactivation. Chem. Eng. J. 2019, 383, 123088. [Google Scholar] [CrossRef]
- Chen, J.J.; Shi, X.T.; Zhu, Y. On-demand storage and release of antimicrobial peptides using Pandora’s box-like nanotubes gated with a bacterial infection-responsive polymer. Theranostics 2020, 10, 109–122. [Google Scholar] [PubMed]
- Zhang, Y.M.; Wang, F.M.; Huang, Q.L. Layer-by-layer immobilizing of polydopamine-assisted ε-polylysine and gum Arabic on titanium: Tailoring of antibacterial and osteogenic properties. Mat. Sci. Eng. C-Mater. 2020, 110, 110690. [Google Scholar] [CrossRef] [PubMed]
- Ye, J.; Li, B.; Li, M. ROS induced bactericidal activity of amorphous Zn-doped titanium oxide coatings and enhanced osseointegration in bacteria-infected rat tibias. Acta Biomater. 2020, 107, 313–324. [Google Scholar] [CrossRef]
- Hang, R.Q.; Zhao, F.L.; Yao, X.H. Self-assembled anodization of NiTi alloys for biomedical applications. Appl. Surf. Sci. 2020, 517, 146118. [Google Scholar] [CrossRef]
- Wang, B.B.; Wu, Z.Z.; Lan, J.P. Surface modification of titanium implants by silk fibroin/Ag co-functionalized strontium titanate nanotubes for inhibition of bacterial-associated infection and enhancement of in vivo osseointegration. Surf. Coat. Tech. 2021, 405, 126700. [Google Scholar] [CrossRef]
- Ren, Y.Z.; Zhao, X.; Liang, X.F. Injectable hydrogel based on quaternized chitosan, gelatin and dopamine as localized drug delivery system to treat parkinson’s disease. Int. J. Biol. Macromol. 2017, 105, 1079–1087. [Google Scholar] [CrossRef]
- Chen, M.; Zhang, Y.; Fu, S. Effect of fluorination/oxidation level of nano-structured titanium on the behaviors of bacteria and osteoblasts. Appl. Surf. Sci. 2020, 502, 144077. [Google Scholar] [CrossRef]
- Yuan, Z.; He, Y.; Lin, C.C. Antibacterial surface design of biomedical titanium materials for orthopedic applications. J. Mater. Sci. Technol. 2021, 78, 51–67. [Google Scholar] [CrossRef]
- Raut, H.K.; Das, R.; Liu, Z.Q. Biocompatibility of biomaterials for tissue regeneration or replacement. Biotechnol. J. 2020, 15, e2000160. [Google Scholar] [CrossRef]
- Zhou, W.; Peng, X.; Ma, Y. Two-staged time-dependent materials for the prevention of implant-related infections. Acta Biomater. 2020, 101, 128–140. [Google Scholar] [CrossRef] [PubMed]
- Baker, M.; Eberhardt, A.; Martin, D. Bone properties surrounding hydroxyapatite-coated custom osseous integrated dental implants. J. Biomed Mater. Res. B 2010, 95, 218–224. [Google Scholar] [CrossRef] [PubMed]
- Becker, K.; Drescher, B.; Honscheid, R. Biomechanical, micro-computed tomographic and immunohistochemical analysis of early osseous integration at titanium implants placed following lateral ridge augmentation using extracted tooth roots. Clin. Oral Implant. Res. 2017, 28, 334–340. [Google Scholar] [CrossRef]
- Auernheimer, J.; Zukowski, D.; Dahmen, C. Titanium implant materials with improved biocompatibility through coating with phosphonate-anchored cyclic RGD peptides. ChemBioChem 2005, 6, 2034–2040. [Google Scholar] [CrossRef] [PubMed]
- Chouirfa, H.; Bouloussa, H.; Migonney, V. Review of titanium surface modification techniques and coatings for antibacterial applications. Acta Biomater. 2019, 83, 37–54. [Google Scholar] [CrossRef]
- Xu, K.; Zhou, M.; Chen, W.Z. Bioinspired polydopamine/graphene oxide/collagen nanofilms as a controlled release carrier of bioactive substances. Chem. Eng. J. 2021, 405, 126930. [Google Scholar] [CrossRef]
- Wang, C.L.; Xiong, S.H.; You, J.Y. Dextran-based coacervate nanodroplets as potential gene carriers for efficient cancer therapy. Carbohyd. Polym. 2020, 231, 115687. [Google Scholar]
- Correia, A.R.; Sampaio, I.; Comparetti, E.J. Optimized PAH/Folic acid layer-by-layer films as an electrochemical biosensor for the detection of folate receptors. Bioelectrochemistry 2021, 137, 107685. [Google Scholar] [CrossRef]
- Ellison, A.J.; Tanrikulu, I.C.; Dones, J.M. A cyclic peptide mimetic of damaged collagen. Biomacromolecules 2020, 21, 1539–1547. [Google Scholar] [CrossRef]
- Cumming, M.H.; Leonard, A.R.; LeCorre-Bordes, D.S. Intra-fibrillar citric acid crosslinking of marine collagen electrospun nanofibres. Int. J. Biol. Macromol. 2018, 114, 874–881. [Google Scholar] [CrossRef]
- Skov, K.; Oxfeldt, M.; Thøgersen, R. Enzymatic hydrolysis of a collagen hydrolysate enhances postprandial absorption rate-A randomized controlled tria. Nutrients 2019, 11, 1064. [Google Scholar] [CrossRef] [PubMed]
- Gregurec, D.; Wang, G.C.; Pires, R.H. Bio inspired titanium coatings: Self-assembly of collagen- alginate films for enhanced osseointegration. J. Mater. Chem. B 2016, 4, 1978–1986. [Google Scholar] [CrossRef] [PubMed]
- Xiao, J.; Ma, Y.H.; Wang, W.H. Incorporation of gelatin improves toughness of collagen films with a homo-hierarchical structure. Food Chem. 2021, 345, 128802. [Google Scholar] [CrossRef]
- Krajewski, A.; Piancastelli, A.; Malavolti, R. Albumin adhesion on ceramics and correlation with their Z-potential. Biomaterials 1998, 19, 637–641. [Google Scholar] [CrossRef] [PubMed]
- Xu, J.; Xu, Z.; Qiao, D. Effect of anionic surfactants on grafting density of gelatin modified with PDMS-E. Colloid Surf. B 2014, 114, 310–315. [Google Scholar] [CrossRef]
- Bello, A.B.; Kim, D.; Kim, D. Engineering and functionalization of gelatin biomaterials: From cell culture to medical applications. Tissue Eng. Part B-Rev. 2020, 26, 164–180. [Google Scholar] [CrossRef]
- Liu, Y.J.; Wu, J.; Zhang, H. Covalent immobilization of the phytic acid-magnesium layer on titanium improves the osteogenic and antibacterial properties. Colloid Surf. B 2021, 203, 111768. [Google Scholar] [CrossRef]
- Ye, J.; Li, B.; Zheng, Y.F. Eco-friendly bacteria-killing by nanorods through mechano-puncture with top selectivity. Bioact. Mater. 2022, 15, 173–184. [Google Scholar] [CrossRef]
- Nespoli, A.; Passaretti, F.; Szentmiklósi, L. Biomedical NiTi and β-Ti Alloys: From Composition, Microstructure and Thermo-Mechanics to Application. Metals 2022, 12, 406. [Google Scholar] [CrossRef]
- Tomar, D.; Chaudhary, S.; Jena, K.C. Self-assembly of L-phenylalanine amino acid: Electrostatic induced hindrance of fibril formation. RSC Adv. 2019, 9, 12596–12605. [Google Scholar] [CrossRef]
- Gao, M.L.; Gua, Z.; Luo, Z.X. One-layer-only molecular deposition filming flooding: A review. Colloid Surf. A 2019, 572, 182–196. [Google Scholar] [CrossRef]
- Yi, R.W.; Mao, Y.Y.; Shen, Y.B. Self-assembled Monolayers for Batteries. J. Am. Chem. Soc. 2021, 143, 12897–12912. [Google Scholar] [CrossRef] [PubMed]
- Tomar, D.; Chaudhary, S.; Jena, K.C. A closer physico-chemical look to the Layer-by-Layer electrostatic self-assembly of polyelectrolyte multilayers. Adv. Colloid Interface Sci. 2020, 282, 102197. [Google Scholar]
- Wang, S.K.; Goronzy, D.P.; Young, T.D. Formation of highly ordered terminal alkyne self-assembled monolayers on the Au(“<Injectable thermosensitive hydrogel-based drug delivery system for local cancer therapy.pdf>,”) surface through substitution of 1 Decaboranethiolate. J. Phys. Chem. C 2019, 123, 1348–1353. [Google Scholar]
- Decher, G. Fuzzy, nanoassemblies: Toward layered polymeric multicomposites. Science 1997, 277, 1232. [Google Scholar] [CrossRef]
- Shi, Q.; Qian, Z.Y.; Liu, D.H. Surface modification of dental titanium implant by layer-by-layer electrostatic self-assembly. Front. Physiol. 2017, 8, 574. [Google Scholar] [CrossRef]
- Krebs, T.; Tan, H.L.; Andersson, G. Increased layer interdiffusion in polyelectrolyte films upon annealing in water and aqueous salt solutions. Phys. Chem. Chem. Phys. 2006, 8, 5462–5468. [Google Scholar] [CrossRef]
- Escobar, A.; Muzzio, N.; Moya, S.E. Antibacterial layer-by-layer coatings for medical implants. Pharmaceutics 2021, 13, 16. [Google Scholar] [CrossRef]
- Wang, P.; Zhang, C.; Zou, Y.C. Immobilization of lysozyme on layer-by-layer self-assembled electrospun films: Characterization and antibacterial activity in milk. Food Hydrocoll. 2021, 113, 106468. [Google Scholar] [CrossRef]
- Xu, S.L.; Niu, X.L.; Xu, J. A multifunctional gelatine-quaternary ammonium copolymer: An efficient material for reducing dye emission in leather tanning process by superior anionic dye adsorption. J. Hazard Mater. 2020, 383, 121142. [Google Scholar] [CrossRef]
- Li, Z.S.; Yang, X.X.; Liu, H. Dual-functional antimicrobial coating based on a quaternary ammonium salt from rosin acid with in vitro and in vivo antimicrobial and antifouling properties. Chem. Eng. J. 2019, 374, 564–575. [Google Scholar] [CrossRef]
- Hussain, A.K.; Sudin, I.; Basheer, U.M. A review on graphene-based polymer composite coatings for the corrosion protection of metals. Corros. Rev. 2019, 37, 343–3635. [Google Scholar] [CrossRef]

| G | |||||||
|---|---|---|---|---|---|---|---|
| Blank | SDScac | SDScmc | SDS6% | STSocac | STSocmc | STSo6% | |
| EPTAC | 3.574 | 3.672 | 3.589 | 5.385 | 5.284 | 5.093 | 7.356 |
| DEQAS | 3.034 | 6.206 | 5.628 | 6.848 | 6.279 | 6.168 | 7.256 |
| MPA-N+ | 3.627 | 5.482 | 5.583 | 5.632 | 5.965 | 6.065 | 6.353 |
| DEQAS/MPA-N+ | 3.145 | 5.629 | 5.868 | 6.353 | 6.846 | 6.735 | 7.325 |
Disclaimer/Publisher’s Note: The statements, opinions and data contained in all publications are solely those of the individual author(s) and contributor(s) and not of MDPI and/or the editor(s). MDPI and/or the editor(s) disclaim responsibility for any injury to people or property resulting from any ideas, methods, instructions or products referred to in the content. |
© 2023 by the authors. Licensee MDPI, Basel, Switzerland. This article is an open access article distributed under the terms and conditions of the Creative Commons Attribution (CC BY) license (https://creativecommons.org/licenses/by/4.0/).
Share and Cite
Song, H.; Xing, L.; Wei, J.; Wang, X.; Yang, Y.; Zhe, P.; Luan, M.; Xu, J. Preparation of Gelatin-Quaternary Ammonium Salt Coating on Titanium Surface for Antibacterial/Osteogenic Properties. Molecules 2023, 28, 4570. https://doi.org/10.3390/molecules28124570
Song H, Xing L, Wei J, Wang X, Yang Y, Zhe P, Luan M, Xu J. Preparation of Gelatin-Quaternary Ammonium Salt Coating on Titanium Surface for Antibacterial/Osteogenic Properties. Molecules. 2023; 28(12):4570. https://doi.org/10.3390/molecules28124570
Chicago/Turabian StyleSong, Hongyang, Lei Xing, Jinjian Wei, Xue Wang, Yaozhen Yang, Pengbo Zhe, Mingming Luan, and Jing Xu. 2023. "Preparation of Gelatin-Quaternary Ammonium Salt Coating on Titanium Surface for Antibacterial/Osteogenic Properties" Molecules 28, no. 12: 4570. https://doi.org/10.3390/molecules28124570
APA StyleSong, H., Xing, L., Wei, J., Wang, X., Yang, Y., Zhe, P., Luan, M., & Xu, J. (2023). Preparation of Gelatin-Quaternary Ammonium Salt Coating on Titanium Surface for Antibacterial/Osteogenic Properties. Molecules, 28(12), 4570. https://doi.org/10.3390/molecules28124570









